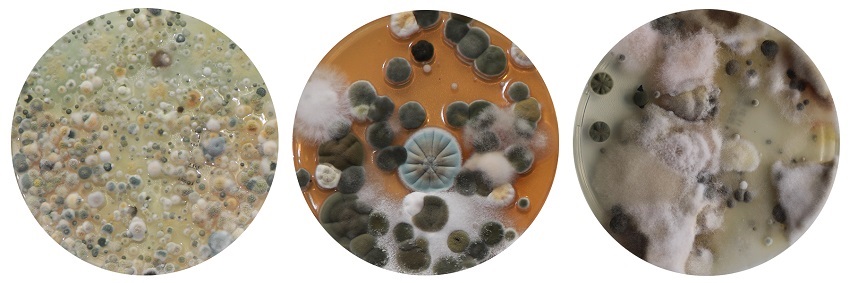
Airlogy

To, čo nás obklopuje a čo každý deň dýchame, by nemalo byť ľahostajné nikomu z nás. Okolité prostredie sa totiž veľkou mierou podpisuje na našom zdraví a mnohokrát si ani neuvedomujeme, že môže spôsobiť vznik rôznych alergií, respiračných ochorení, ale aj zapríčiniť dlhodobé pocity únavy a podráždenie. Na podrobnú analýzu našich domovov, kancelárií aj miest, kde trávime veľké množstvo času, slúži špeciálna testovacia súprava Airlogy, pomocou ktorej ľahko a rýchlo zistíte, či nežite v nezdravom prostredí, a zároveň získate potrebné odporúčanie, ako svoje zdravie čo najlepšie chrániť.

Testovacia súprava Airlogy slúži na detailnú analýzu prostredia, v ktorom trávime každý deň väčšinu svojho času. Či už doma alebo v kancelárii, všade okolo nás sa nachádzajú mikroorganizmy v podobe baktérií, plesní či kvasiniek, ktoré voľným okom nevidíme, a ktoré pri zvýšenej koncentrácii nepriaznivo ovplyvňujú až ohrozujú naše zdravie. Hotovým rajom sú pre ne predovšetkým vlhké miesta, nevetrané priestory či zanedbaná vzduchotechnika, zachytávajú sa však aj na stenách, interiérovom vybavení aj okolitom prachu. Môžu tak prispievať k vzniku alergií, chronických dýchacích ťažkostí, dlhodobej únavy aj celkovej psychickej nepohody.
Vďaka domácej testovacej súprave Airlogy tak môžete zistiť, či práve vy a vaša rodina nie ste vystavení takémuto riziku, prípadne môžete odhaliť miesta častého výskytu patogénov a následne podľa odborného odporúčania predísť ich výskytu a celkovo ozdraviť prostredie vášho domova.

Testovanie s Airlogy je veľmi jednoduché a nezaberie vám viac ako niekoľko desiatok minút. Súčasťou testovacej súpravy je aj podrobný návod, ako krok za krokom postupovať a na aké miesta v domácnosti sa pri testovaní zamerať. Stačí si len naskenovať QR kód na zadnej strane škatuľky, ktorý obsahuje podrobnú inštruktáž celého procesu.


Vďaka podrobnej analýze získate prehľad o tom, aké presné druhy a aké množstvo baktérií, plesní a kvasiniek sa nachádza vo vašom okolí. Ďalej vám bude navrhnuté vhodné riešenie, ako účinne eliminovať výskyt týchto mikroorganizmov aj to, akým spôsobom postupovať, aby ste dlhodobo udržali zdravé prostredie vašej domácnosti.

Nebuďte ľahostajní voči svojmu zdraviu. Poznajte dokonale prostredie, v ktorom žijete, a zbavte sa všetkých nebezpečných a ohrozujúcich patogénov.